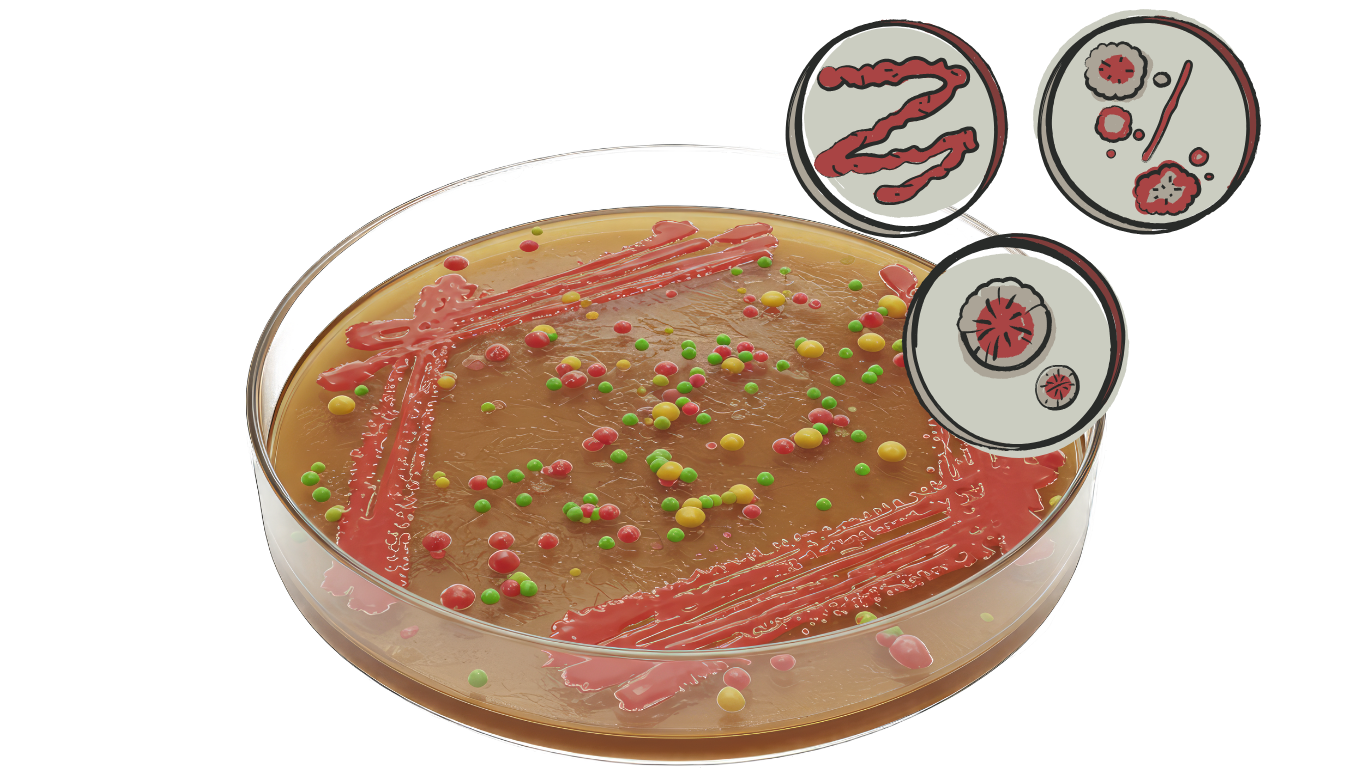
baktérium tenyésztés

VÁRANDÓSGONDOZÁS
Foglaljon időpontotA 9 HÓNAP CSODÁJA:
BIZTONSÁG ÉS TÁMOGATÁS a FOGANTATÁSTÓL A SZÜLETÉSIG
A várandósság kilenc hónapja nem csupán időszak, hanem egy életre szóló utazás kezdete. Minden pillanata egy apró csoda: a szív első dobbanásától a kis rúgásokig, az anyai szívben lassan kibontakozó szeretettől a világra érkező új életig.
Ebben a folyamatban a kismama nemcsak testében, hanem lelkében is otthont ad a gyermekének. Az ő egészsége, biztonsága és nyugalma jelenti az alapot a baba fejlődéséhez. Ezért a várandósgondozás nem csupán orvosi vizsgálatok sora – hanem a biztonság és a szeretet hálója, amely körbeöleli az anyát és a születendő kis életet.
Miért fontos a várandósgondozás?
A várandósság minden nő életében különleges időszak, amely számos testi és lelki változással jár. A baba egészséges fejlődésének és az édesanya jóllétének biztosítása érdekében kiemelten fontos a rendszeres várandósgondozás.
Ez nem csupán vizsgálatok sorozatát jelenti, hanem személyre szabott figyelmet, megelőzést és biztonságot is.
A várandósgondozás célja
-
a magzat egészséges fejlődésének nyomon követése;
-
a várandós anya testi és lelki állapotának ellenőrzése;
-
a szövődmények (pl. terhességi cukorbetegség, magas vérnyomás, koraszülés) időben való felismerése;
-
felkészítés a szülésre és a gyermekágyas időszakra.
A várandósság útja egyszerre meghitt és felelősségteljes. A gondozás során orvos, védőnő és család együtt vigyáz arra, hogy a baba biztonságban, szeretetben érkezzen a világra. Minden kontroll, minden vizsgálat egy apró lépcsőfok a születés boldog pillanatához.
Hogyan épül fel a várandósgondozás?
A várandósgondozás ütemezett vizsgálatokból áll, amelyek trimeszterek szerint szerveződnek. Általános érvénnyel irányadó, hogy a 30. hétig 4 hetente, majd a 36. hétig 3 hetente, utána hetente ajánlott a várandósgondozási vizsgálatokon való részvétel. Ettől esetenként eltérünk, ha az egyéni szükség úgy kínánja. Kérjük, minden alkalomra hozza magával a gondozási kiskönyvét, meglévő leleteit, illetve a vérvételekre éhgyomorral, az ultrahangvizsgálatokra pedig lehetőleg közepesen telt húgyhólyaggal kell megjelenni.
Első trimeszter (0–12. hét)
-
Első vizsgálat: a terhesség megállapítása nőgyógyászati vizsgálattal, ultrahanggal
-
Vér- és vizeletvizsgálat (alap labor, fertőzések szűrése, vércsoport meghatározás)
-
Első genetikai ultrahang (12. hét, tarkóredő-mérés, Down-szűrés)
-
Életmód-tanácsadás: vitaminpótlás (pl. folsav), táplálkozás, mozgás
Második trimeszter (13–27. hét)
-
18–20. heti genetikai ultrahang: részletes szervi vizsgálat
-
Vércukorterhelés (24–26. hét között a terhességi cukorbetegség szűrésére)
-
Vérnyomás, testsúly, vizelet rendszeres ellenőrzése
-
Anya közérzetének, panaszainak megbeszélése
Harmadik trimeszter (28. héttől a szülésig)
-
Növekedési ultrahang (30–32. hét)
-
CTG (magzati szívhang- és méhösszehúzódás-mérés) a 36. héttől rendszeresen
-
Streptococcus B-szűrés (35–37. hét)
-
Szülésre való felkészítés, szülési terv átbeszélése
Miért elengedhetetlen a rendszeres gondozás?
A várandósgondozás során olyan problémák derülhetnek ki időben, amelyek kezelés nélkül veszélyeztethetik az anya és a baba egészségét. Ilyenek lehet például
-
a terhességi magas vérnyomás (preeclampsia),
-
a vérszegénység,
-
a fertőzések,
-
fejlődési rendellenességek.
A rendszeres ellenőrzés biztonságot nyújt a családnak, és segít felkészülni a szülésre is.
A kilenc hónap során a kismama szíve alatt formálódik egy új élet. A várandósgondozás biztosítja, hogy ez az időszak ne félelmekkel, hanem örömteli várakozással teljen. Hogy a szülés napján ne csak egy baba szülessen meg, hanem egy új anya és egy új család is.
Terhesség megállapítása
Mikor: 5-7. hét körül (első trimeszter)
Vér- és vizeletvizsgálatok
Mikor: mindhárom trimeszterben, ismételve
Genetikai ultrahang és szűrések
Mikor: első genetikai ultrahang 11-13. héten; második genetikai ultrahang 18-20. héten; opcionális további genetikai tesztek 10-30. hét között
Terheléses vércukorvizsgálat (OGTT)
Mikor: 24-26. héten (második trimeszter vége)
Ultrahangvizsgálatok a magzat és lepény állapotának ellenőrzésére
Mikor: 18-20. héten (II. trim.), 30-32. héten (III. trim.)
Állapotellenőrzések
Vérnyomás, testsúly stb. – folyamatosan
Streptococcus B szűrés
Mikor: Második és harmadik trimeszter (20 és 36. hét körül)
CTG (kardiotokográfia) vizsgálat
Mikor: Harmadik trimeszter, 36. héttől hetente
Fogászati vizsgálat
Mikor: Első trimeszterben vagy a terhesség során

Az első ultrahang az egyik legelső és legfontosabb vizsgálat, amely hüvelyi ultrahang segítségével történik a 5-7. terhességi héten.
Célja a terhesség méhben való pontos megerősítése, a magzati életjelek (szívverés) kimutatása, valamint a terhesség korának meghatározása.
Ebben az időszakban megállapítható, hogy egy vagy több magzat van-e, illetve kizárhatók méhen kívüli terhesség veszélyei.
Egy nagyon fontos, nyugtató pillanat ez a kismamák számára, ahol orvosuk szakértelmére és empátiájára támaszkodva megélhetik a bizonyosságot, hogy minden rendben van.

A vérvizsgálat során meghatározzák a vércsoportot, Rh-ellenanyag, és szűrnek fertőzésekre, mint a hepatitis B, szifilisz, toxoplazms, citomegalovírus, rubeola, HSV1, HSV2 (TORCH), hogy időben meg tudják előzni a magzatra vagy anyára veszélyes szövődményeket.
Ellenőrzik a vashiányt, hiszen a megfelelő oxigénszállítás kritikus a magzat megfelelő fejlődéséhez.
A vizeletvizsgálat húgyúti fertőzések, cukor- vagy fehérjevizelés szűrésére szolgál, melyek korai kezelése megakadályozza a komplikációkat.
Az eredményekről a gondozó orvos részletesen tájékoztat, támogatva a kismama lelki egészségét azáltal, hogy minden kérdésére türelmesen válaszol.
Az első trimeszteri genetikai ultrahang
egy nagyon precíz és összetett vizsgálat. Ebben az időszakban az orvos megvizsgálja a magzat szívműködését, az ülőmagasságot (CRL), ami alapján a terhesség pontos korát meg tudja határozni, valamint a magzati anatómia korai jeleit.
Különösen fontos a kromoszóma-rendellenességek – például a Down-szindróma – szűrése: mérik a tarkóredő (NT) vastagságát, ellenőrzik az orrcsont meglétét, valamint a ductus venosus és a tricuspidális billentyű vérellátását. Ezek az értékek a magzat egészségének fontos indikátorai.
A vizsgálat során az orvos nem csupán technikai „ellenőrzést” végez, hanem empátiával fordul a kismamahoz, aki gyakran nagy izgalommal érkezik. A szakavatott nőgyógyász megnyugtató jelenléte, a vizsgálat részletes és türelmes magyarázata erősíti a kismama biztonságérzetét és segít megőrizni a lelki nyugalmát ebben a különleges időszakban.
A második genetikai ultrahang
a 18-22. héten már a magzat fejlett szervezetének részletes vizsgálatára fókuszál: a fejkörfogatot, haskörtérfogatot, csontok és végtagok méreteit mérik, a gerinc, a szív, a has és mellkas szerveit nézik át alaposan, és ellenőrzik a méhlepény helyzetét, a magzatvíz mennyiségét is.
Kiterjesztett genetikai szűrés
Kiterjesztett genetikai szűréshez a vizsgálatot vérvétellel kombinálják (például kombinált teszt vagy Non Invazív Prenatális Teszt, NIPT), amelyekből kromoszóma-eltérések vagy ritka genetikai betegségek kockázata is megállapítható.
Ezek az eredmények további biztonságot adnak a várandósnak.
A genetikai ultrahang nem csupán egy rutin vizsgálat, hanem egy lehetőség a tudatos felkészülésre, amikor az orvos a legszükségesebb információkat átadva támogatja a kismamát. Ez különösen fontos, hiszen a vizsgálatok leletei lehetnek megnyugtatók vagy nehéz döntéseket is előidézhetnek, amelyekhez szükség van szakmai segítségre és emberi támogatásra egyaránt.
A terheléses vércukorvizsgálat (OGTT) a terhességi cukorbetegség kiszűrésére végzett laboratóriumi vizsgálat, amely során a terhes nőt megterhelik glükózzal, és mérik a vércukorszint változását.
A vizsgálat során a kismama meghatározott mennyiségű glükózt iszik meg, majd a vércukorszint változását több időpontban mérik. Az eredmények segítenek időben felismerni a cukoranyagcsere zavart, amely nélkülözhetetlen a magzat megfelelő fejlődése és az anya egészségének megőrzése szempontjából.
A kismamák számára fontos a vizsgálatról előre tájékoztatást kapni, stresszoldó magyarázatokat, és az orvosi támogatást, hiszen néhány esetben életmódváltás vagy kezelés szükséges.

A második trimeszteri, úgynevezett anatómiai ultrahang vizsgálat a magzat szervek részletes átvizsgálását jelenti, amely a működési és anatómiai eltérések szűrésében kiemelt jelentőségű.
A magzat pontos méreteit, a koponya, szív, vesék és végtagok állapotát értékelik, valamint a méhlepény elhelyezkedését és a magzatvíz mennyiségét is mérik.
A harmadik trimeszteri ultrahang ezen túl a magzat növekedésének, súlyának követésére, az esetleges rizikófaktorok felismerésére szolgál.
Az orvos magyarázata, biztató szavai, valamint a vizsgálat során a magzat mozgásának érzékelése gyakran pozitív, lelki erőt adó élményt jelent a várandósnak.

Rendszeres vérnyomásmérés célja a terhességi magasvérnyomás (preeclampsia) korai felismerése, amely jelentős kockázatot jelenthet az anya és a magzat egészségére nézve.
A testsúly nyomon követésével ellenőrzik a megfelelő terhességi súlygyarapodást, elkerülve a túlzott hízást vagy az elmaradt növekedést, mely beidegződés szerint mindkettő káros.
Ezek a mérések gyors, fájdalommentes vizsgálatok, melyek eredményeiről az orvos folyamatosan tájékoztatja a kismamát, aki így aktív részese lehet egészsége megőrzésének.
Hüvelyváladékból vett minta vizsgálata a Streptococcus B baktérium jelenlétének kimutatására, ami a szülés alatti fertőzési kockázatot csökkenti.
A hüvelyi és végbélnyílásból vett kenet segítségével mutatják ki a Streptococcus B baktérium jelenlétét, amely a szülés során súlyos fertőzéseket okozhat a csecsemőnél. Pozitív lelet esetén az orvos időben antibiotikum-kezelést javasol a szülés során, hogy megvédje az újszülöttet.
A vizsgálat fájdalommentes, hasznossága életeket menthet, mert a megfelelő időben adott kezelés megakadályozza a súlyos fertőzéseket.

A magzati szívhang és a méhösszehúzódások monitorozása, ami segít a magzati jólét és a méh működésének nyomon követésében.
CTG segítségével monitorozzák a magzat szívhangját és a méhösszehúzódások gyakoriságát, ami a magzat jólétének legfontosabb jele.
A vizsgálat nem invazív, két érzékelővel végzik, és segít időben felismerni az oxigénhiányt vagy a magzati stresszt. A kismamák számára megnyugtató a rendszeres kontroll, hiszen az orvosok szakértelme és odafigyelése közvetlen biztonságérzetet jelent.

A várandósság alatt megnő a fogászati problémák kockázata, így fontos a fogak állapotának vizsgálata és szükség esetén kezelése.
A terhesség alatt a hormonális változások miatt megnő a fogínygyulladás és fogszuvasodás kockázata. A rendszeres fogászati ellenőrzés és szükség szerinti kezelés segít megelőzni az anyai szervezet gyulladásos állapotát, amely negatívan befolyásolhatja a magzati fejlődést is. A fogorvos és a nőgyógyász együttműködése alapvető a kismama egészségének megőrzésében. Ez a vizsgálat szintén támogató, prevenciós célú.
A Nord Clinic-ben a várandósgondozás része a fogászati vizsgálat és állapotfelmérés, amelyet házon belül, helyben és a várandósgondozás részeként díjmentesen biztosítunk. Részletekkel a szakorvosa szolgál.

SZAKEMBEREINK
szülész-nőgyógyász szakorvosaink
Foglaljon időpontot választott orvosához!

Dr. Jenei Lóránd
alapító, szülész-nőgyógyász szakorvos

Dr. Kása Dániel
szülész-nőgyógyász szakorvos

Dr. Király Anna
szülész-nőgyógyász

Dr. Szemerey Ákos
szülész-nőgyógyász szakorvos

Dr. Zakariás Anita
Szülész-nőgyógyász szakorvos
+36 70 575 6202
Kérdése van? Panasza van? Forduljon bizalommal szakorvosainkhoz!
Szülész-nőgyógyász szakorvosi támogatás önnek
Hívja recepciónkat a +36 70 575 6202 telefonszámot nyitvatartási időben, vagy foglaljon időpontot szakorvosainkhoz online!
